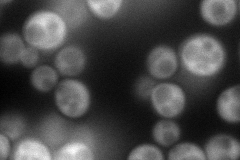
YER052C
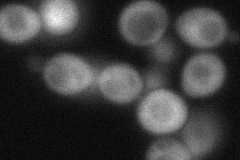
YER052C
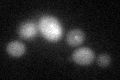
YER052C

View description
Aspartate kinase (L-aspartate 4-P-transferase); cytoplasmic enzyme that catalyzes the first step in the common pathway for methionine and threonine biosynthesis; expression regulated by Gcn4p and the general control of amino acid synthesis
Localization:
Intensity:
Fold change:
Significance:
-
C’ GFP library in SD

below threshold15.32 -
N' NOP1pr-GFP in SD
cytosol133.159 -
N' TEF2pr-mCherry in SD

cytosol176.023 -
N' NATIVEpr-GFP in SD

cytosol91.4604 -
N' TEF2pr-VC and Cyto-VN in SD
cytosol74.3852 -
C’ GFP library in SD+DTT
cytosol17.371.13No -
C’ GFP library in SD+H2O2

cytosol17.491.14No -
C’ GFP library in Starvation Media

cytosol15.170.98No -
C’ GFP library on the background of Pup2-DaMP

below threshold -
C’ GFP library on the background of CCT mutant

below threshold16.75291.09289No
